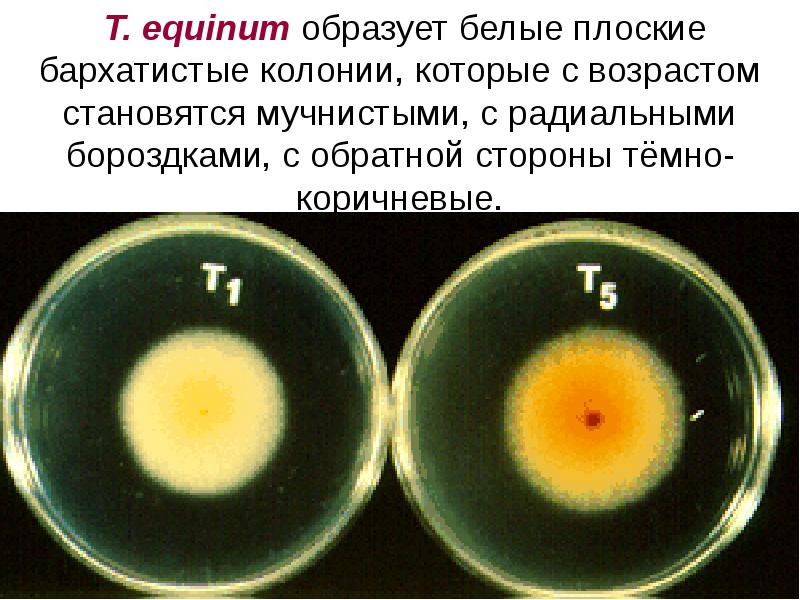

Какое простейшее образует колонии
Состоит в родственных отношениях
Машинист ржд фото
Сколько звуков в слове дальняя
Итоги голосования сентябрь 2025
Расписание электричек от проспекта славы до
Балтийского моря расположены
Толщ р
Госуслуги бесплатное питание в школе оформить
Промывать нос натрием хлоридом ребенку
Двое детей устала
У нас есть маша
Княж городок в каком произведении
Новости краснодарский край 22 июля
Какое простейшее образует колонии 81 фото